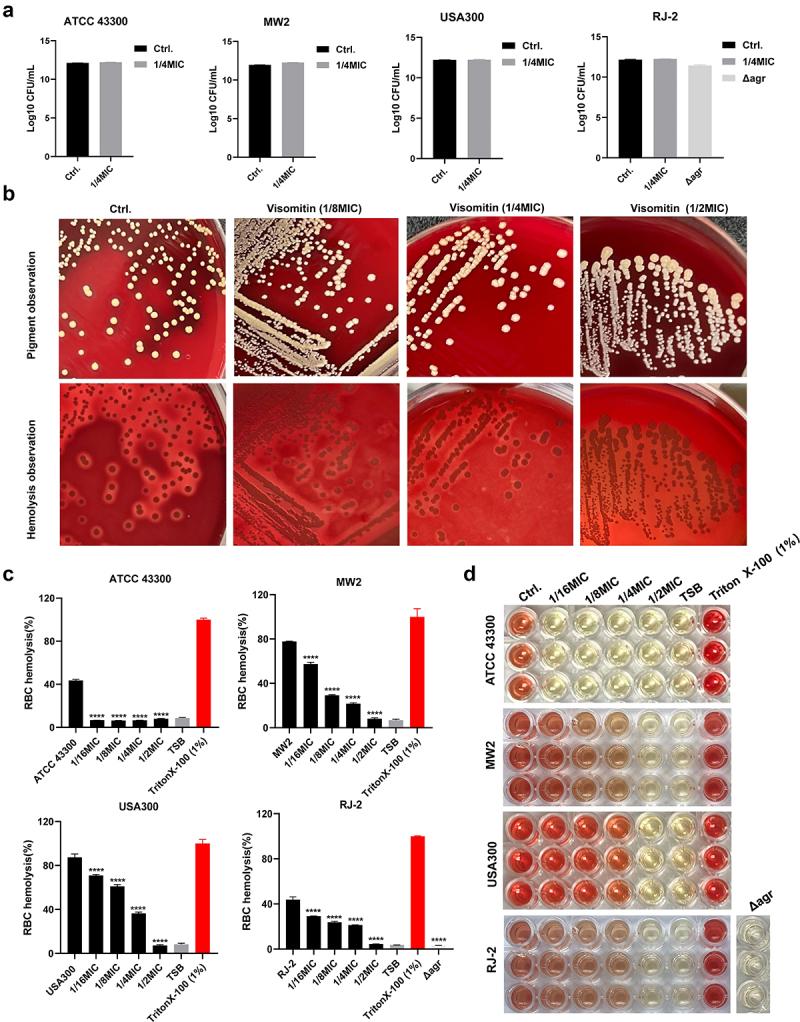
https://cdn.ncbi.nlm.nih.gov/pmc/blobs/df6b/11492638/29f55870347f/KVIR_A_2415952_F0003_OC.jpg

重新利用药物 Visomitin 对. 的杀菌和抗群体感应活性。
Bactericidal and anti-quorum sensing activity of repurposing drug Visomitin against .
机构信息
Department of Laboratory Medicine, The Third Xiangya Hospital of Central South University, Changsha, China.
出版信息
Virulence. 2024 Dec;15(1):2415952. doi: 10.1080/21505594.2024.2415952. Epub 2024 Oct 19.
With the growing antibiotic resistance in , it is imperative to develop innovative therapeutic strategies against new targets to reduce selective survival pressures and incidence of resistance. In , interbacterial communication relies on a quorum sensing system that regulates gene expression and physiological activities. Here, we identified that Visomitin, an antioxidant small molecule, exhibited bactericidal efficacy against methicillin-resistant and its high tolerance phenotypes like intracellular bacteria and persister cells without inducing resistance. Critically, sub-minimal inhibitory concentrations (sub-MICs) of Visomitin could serve as a potent quorum-quencher reducing virulence production (such as haemolysin and staphyloxanthin), along with inhibiting biofilm formation, self-aggregation, and colony spreading of . These effects were probably mediated by interfering with the accessory gene regulator quorum sensing system. In summary, our findings suggest that Visomitin shows dual antimicrobial effects, including bactericidal effects at the concentrations above MIC and quorum sensing inhibition effects at sub-MICs, which holds promise for treating MRSA-related refractory infections.
随着抗生素耐药性的不断增加,开发针对新靶点的创新治疗策略以降低选择性生存压力和耐药性的发生至关重要。在 中,细菌间的通讯依赖于群体感应系统,该系统调节基因表达和生理活动。在这里,我们发现抗氧化小分子 Visomitin 对耐甲氧西林金黄色葡萄球菌及其高耐受表型(如胞内菌和持久细胞)具有杀菌功效,而不会诱导耐药性。重要的是,亚最小抑菌浓度 (sub-MIC) 的 Visomitin 可以作为一种有效的群体感应抑制剂,减少毒力产物(如溶血素和葡萄球菌黄素)的产生,同时抑制生物膜形成、自聚集和 的菌落扩散。这些作用可能是通过干扰辅助基因调节群体感应系统介导的。总之,我们的研究结果表明,Visomitin 具有双重抗菌作用,即在 MIC 以上浓度时表现出杀菌作用,在 sub-MIC 时表现出群体感应抑制作用,这为治疗 MRSA 相关难治性感染提供了希望。